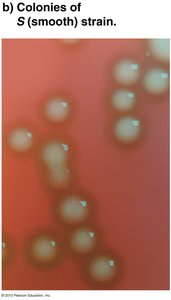
Colonies of S (smooth) strain
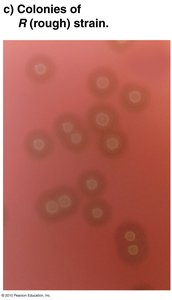
Colonies of R (rough) strain

BackThe Chemical and Physical Structure of the Genetic Material: Key Experiments and Concepts
Study Guide - Smart Notes
Tailored notes based on your materials, expanded with key definitions, examples, and context.
The Chemical and Physical Structure of the Genetic Material
Introduction to Genetics
Genetics is the scientific study of the origin, transmission, and expression of genetic information. This information is encoded in genes, which are passed from one generation to the next, serving as the source of variability among organisms. The foundation of genetics lies in understanding the nature and structure of DNA, the molecule responsible for inheritance.
Criteria for Genetic Material
For a molecule to serve as genetic material, it must fulfill several essential criteria:
Ability to replicate accurately: The genetic material must be able to make precise copies of itself for transmission to offspring.
Capable of change (evolution): It must allow for mutations and recombination, enabling evolution.
Store information: It must contain the instructions necessary for the development and functioning of an organism.
Express information: The information must be accessible for cellular processes, such as protein synthesis.
Discovery of DNA as the Hereditary Material
Timeline of Key Experiments
The identification of DNA as the genetic material was achieved through a series of landmark experiments:
1890: Weismann proposed that substances in cell nuclei control development.
1900: Chromosomes were shown to contain hereditary information and to be composed of proteins and nucleic acids.
1928: Griffith's Transformation Experiment demonstrated the transfer of genetic traits between bacterial strains.
1944: Avery's Transformation Experiment identified DNA as the transforming agent.
1950-52: Chargaff's Nucleotide Ratio Observations provided evidence for DNA's structure.
1953: Hershey-Chase Bacteriophage Experiment confirmed DNA as the genetic material.
1953: Franklin and Wilkins used X-ray crystallography to study DNA structure.
1953: Watson & Crick proposed the double-helix model of DNA.
Griffith's Transformation Experiments (1928)
Frederick Griffith investigated the nature of the genetic material using two strains of Streptococcus pneumoniae:
S (smooth) strain: Virulent, forms smooth colonies due to a polysaccharide capsule.
R (rough) strain: Nonvirulent, forms rough colonies lacking the capsule.

Griffith's experiment involved injecting mice with different combinations of these strains:
Mice injected with live S strain died.
Mice injected with live R strain survived.
Mice injected with heat-killed S strain survived.
Mice injected with live R strain and heat-killed S strain died, and live S strain bacteria were recovered.
This demonstrated the "transforming principle," where genetic material from the dead S strain transformed the R strain into a virulent form.

Avery, MacLeod, and McCarty's Transformation Experiments (1944)
Building on Griffith's work, Avery and colleagues isolated DNA, RNA, and proteins from S strain bacteria to determine which component was responsible for transformation. They treated extracts with enzymes that destroyed either DNA or RNA:
When DNA was destroyed, transformation did not occur.
When RNA was destroyed, transformation still occurred.
They concluded that DNA is the transforming agent responsible for transmitting genetic information.

Hershey-Chase Bacteriophage Experiment (1953)
Hershey and Chase used bacteriophages (viruses that infect bacteria) to determine whether DNA or protein is the genetic material. Bacteriophages consist of a protein coat and DNA core.

They labeled phage DNA with radioactive phosphorus (32P) and protein with radioactive sulfur (35S), then allowed the phages to infect bacteria:
32P-labeled DNA entered the bacteria and was found in progeny phages.
35S-labeled protein remained outside the bacteria and was not transmitted to progeny.


This experiment provided strong evidence that DNA, not protein, is the genetic material.
Chemical Composition and Organization of DNA
Structure of DNA
DNA is composed of nucleotides, each containing a phosphate group, a deoxyribose sugar, and a nitrogenous base (adenine, thymine, cytosine, or guanine). The nucleotides are linked to form a double helix, with complementary base pairing (A with T, C with G) and a sugar-phosphate backbone.
Double helix: Two strands of DNA wind around each other, held together by hydrogen bonds between bases.
Chromosome organization: DNA is packaged into chromosomes within the cell nucleus.

Key formula: The base pairing rule can be summarized as:
Chargaff's rules state that the amount of adenine equals thymine, and the amount of cytosine equals guanine in DNA.
Summary Table: Key Experiments Identifying DNA as Genetic Material
Experiment | Organism/System | Key Finding |
|---|---|---|
Griffith (1928) | Streptococcus pneumoniae (mice) | Transformation of nonvirulent to virulent strain; "transforming principle" exists |
Avery et al. (1944) | Streptococcus pneumoniae | DNA is the transforming agent |
Hershey-Chase (1953) | Bacteriophage T2, E. coli | DNA, not protein, is the genetic material |
Conclusion
The identification of DNA as the genetic material was a pivotal moment in genetics, laying the foundation for understanding inheritance, genetic variation, and molecular biology. The experiments described above demonstrate the rigorous scientific process used to uncover the chemical and physical nature of genetic material.